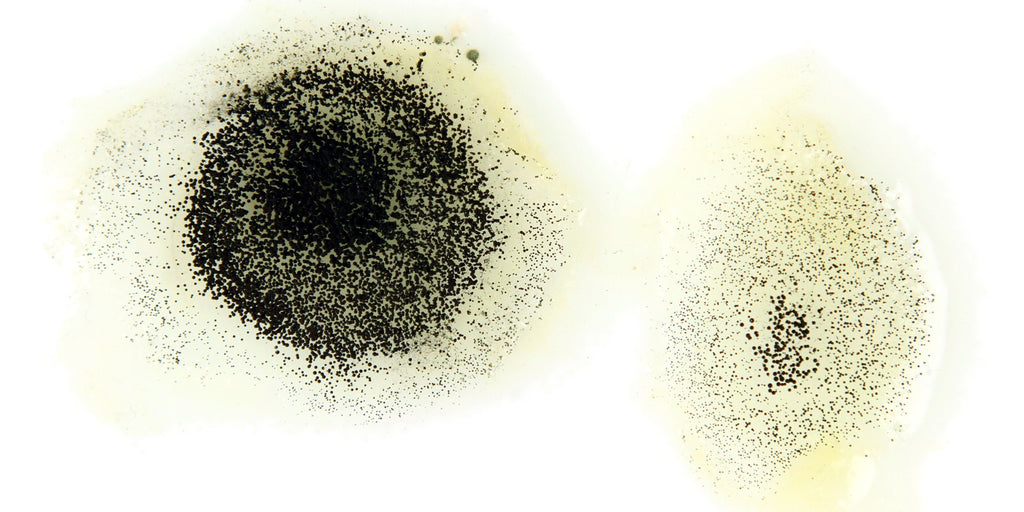
Preservatives in Skincare: What’s Safe, What’s Hype, and Why It All Matters

Preservatives in Skincare: What’s Safe, What’s Hype, and Why It All Matters
Preservatives. Few words cause more panic in skincare than this one.
They've been blamed for everything from hormone disruption to skin irritation to marine toxicity. But ask most people what a preservative actually does, and you’ll hear crickets.
Let’s clear the air once and for all. This is your comprehensive guide to preservatives in skincare — what they do, why you need them, and how to navigate the noise.
What Are Preservatives, Really?
Preservatives are ingredients that prevent microbial growth and rancidity in personal care products. Without them, water-based skincare would spoil within days.
This is not theoretical. It's microbiology.
Even in pristine lab conditions, the moment water enters a formula, it becomes a buffet for bacteria, yeast, and mold. Leave a preservative-free product in your warm, steamy bathroom and you’re practically running a petri dish.
Preservatives extend shelf life, ensure user safety, and keep products from becoming biological hazards.
The Danger of "Preservative-Free"
Clean beauty brands love to brag: *"No preservatives!"
But in most cases, that just means: *"This product is one steamy shower away from contamination."
Unpreserved or under-preserved products have led to FDA recalls, serious infections, and dermatological outbreaks. Because when microbes grow in your moisturizer? That’s not clean. That’s dangerous.
Natural products, ironically, are even more prone to contamination. Why? They contain more bioavailable nutrients (plant extracts, sugars, proteins), which microbes love just as much as your skin does.
And while some of these "natural preservatives" sound nice on the label, they often require high concentrations that can increase irritation risk, raise cost, and shorten shelf life.
Do All Products Need Preservatives?
No. But most do.
Products That Don't Require Preservatives:
-
Oil-only formulas (no water = no microbial party)
-
High/low pH products (like some bar soaps)
-
Aerosol packaging (little to no air or contact exposure)
But as soon as there's water, or your fingers dip into a jar? Preservation becomes essential.
Preservative Types: The Truth Behind the Labels
Let’s walk through the most common classes of preservatives, what the science says, and what the public thinks they do.
1. Parabens (e.g., methylparaben, propylparaben)
-
Pros: Extremely effective at low doses; especially against fungi. Long safety record and regulatory scrutiny.
-
Cons: Often require co-preservatives; declining use due to public pressure.
-
Myth: "Parabens cause breast cancer."
Debunked: This myth gained traction after a 2004 study found trace parabens in breast tumor tissue. But here’s what rarely gets explained: that study was observational, did not establish causation, and did not include a control group of healthy tissue. It didn’t prove that parabens caused cancer — only that they were present. The authors themselves clarified this.
Multiple global regulatory bodies, including the FDA, European Medicines Agency, and Scientific Committee on Consumer Safety (SCCS), have evaluated parabens extensively and concluded they are safe for use in cosmetics at low concentrations [1,2].
In fact, parabens have lower allergenic potential than many "natural" preservatives currently popular in clean beauty.
2. Organic Acids (e.g., sodium benzoate, potassium sorbate)
-
Pros: "Natural" perception; good against mold/yeast.
-
Cons: Weak against bacteria; pH-dependent; more temperamental.
-
Myth: "If it’s food-safe, it must be safe in skincare."
Debunked: While these are common food preservatives, their effectiveness in skincare depends on pH and formulation context. A product that smells nice and feels gentle could still fail microbiological testing if its pH isn’t optimized or packaging doesn't minimize contamination. And ironically, some of these so-called "gentler" acids can be more irritating to sensitive skin than parabens.
3. Dehydroacetic Acid + Benzyl Alcohol (e.g., Geogard 221)
-
Pros: Popular phenoxyethanol alternative; broader coverage.
-
Cons: Can sting on compromised skin; often needs help (chelators, glycols).
-
Myth: "Benzyl alcohol is natural, so it must be safe."
Debunked: Benzyl alcohol is naturally found in some fruits and teas. But it can also be irritating at higher concentrations. Natural origin doesn’t negate the potential for sensitization, especially for people with eczema or compromised barriers. Just because an ingredient is naturally derived doesn't make it universally safe.
4. Preservative Boosters (e.g., ethylhexylglycerin, caprylyl glycol)
-
Pros: Boost antimicrobial efficacy; enhance skin feel.
-
Cons: Rarely sufficient alone. Risk of products passing initial testing but failing in real use.
-
Myth: "Boosters aren’t preservatives, so they’re safer."
Debunked: Many clean brands market boosters as if they don't count as preservatives — a tactic to dodge consumer concern. But if an ingredient is used to prevent microbial growth? It’s acting like a preservative, no matter what the label says. And while these ingredients can be helpful in a system, relying on them alone is risky.
5. Phenoxyethanol
-
Pros: Broad-spectrum; stable; globally approved; found naturally in green tea.
-
Cons: Some people report irritation (especially at 1%); often misunderstood.
-
Myth: "Phenoxyethanol is toxic to humans and builds up in the body."
Debunked: This concern originated from a 2008 French health authority warning about overexposure in infants — not adults. The context was very high use levels in baby wipes, not properly formulated skincare.
In reality, phenoxyethanol is metabolized in the liver and excreted efficiently. Its NOAEL (no-observed-adverse-effect level) is very high, and it has been approved by the EU, FDA, and Japan for leave-on cosmetics at up to 1% [3,4].
For context, ethanol — the alcohol in wine — is more potent and toxic in large quantities, but it doesn’t alarm the public in the same way. Names trigger fear more than function.
What If You’re Still Skeptical?
We get it. If you’ve been steeped in clean beauty marketing, the idea of trusting a "chemical" can feel risky.
But the truth is, most fear around preservatives comes from misinterpretation, misinformation, and marketing incentives. Brands gain more by selling fear than by explaining science.
And if you ever fell for one of those messages? You’re not alone. We did too.
But facts, not fear, are what protect your skin.
The Real Risk? No Preservative at All
Preservatives aren't optional. They’re public health tools.
The fear of chemicals has led to a new problem:
People avoiding preservatives entirely and exposing themselves to bacterial overgrowth, mold, and rancid ingredients.
You don’t want E. coli in your eye cream. Or black mold in your serum. Or rancid oils triggering inflammation.
That’s not "clean." That’s contaminated.
What You Should Look For
✅ Transparency
-
Does the brand tell you what preservative system they use?
-
Are they clear about why?
✅ Compatibility
-
Does the product match your skin type and sensitivities?
✅ Packaging
-
Pumps and tubes > jars (less air + fewer fingers = less risk)
✅ Science Over Slogans
-
If a brand claims to be "preservative-free"... ask how they prevent microbial growth.
Why We Use Phenoxyethanol (and Why It Matters)
There are two choices:
-
Use nothing (dangerous).
-
Use a natural system (limited efficacy, shorter shelf life, higher allergenic risk).
We chose the third option: a proven, globally accepted preservative that works.
Phenoxyethanol is stable. Broad-spectrum. Compatible with sensitive skin (in the vast majority of cases). And backed by global scientific review.
We use it not because it’s trendy — but because it’s trustworthy.
Bottom Line
Preservatives aren’t the enemy. They’re the unsung heroes keeping your skincare safe, stable, and effective.
Preservatives deserve better PR. Because without them, your skincare would be doing the opposite of what you bought it for.
Stay smart. Stay skeptical. And let science, not slogans, guide your skin.
SOURCES
[1] Golden R, et al. "A review of the endocrine activity of parabens and implications for potential risks to human health." Critical Reviews in Toxicology, 2005.
[2] SCCS Opinion on parabens. European Commission, 2011.
[3] CIR Final Report on Phenoxyethanol. Cosmetic Ingredient Review, 2007. [4] Soni MG, et al. "Safety assessment of phenoxyethanol." Food and Chemical Toxicology, 2001.
